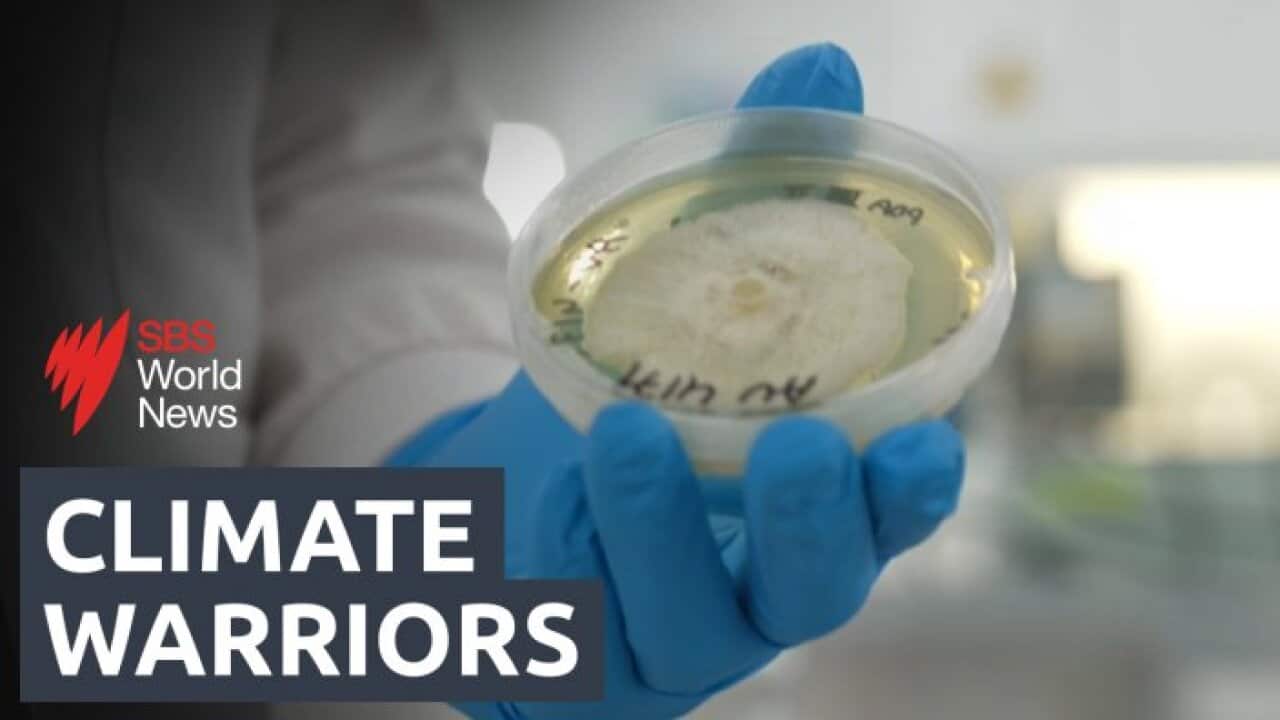

Majority of extreme weather events worsened by climate crisis
The latest iteration of a Carbon Brief analysis has found that 74pc of extreme weather events were made more likely or more severe because of climate change – including “multiple cases” where extreme events were “virtually impossible” without human influence on global temperatures
#ClimateChange #GlobalBurning #ClimateDestruction #ClimateSuicide #MassExtinction #pollution #ecology #environment #climate
Silicon Republic
Majority of extreme weather events worsened by climate crisis
74pc of extreme weather events were made more likely or severe because of climate change, Carbon Brief data finds.